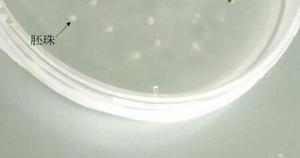
甘藍型油菜與甘藍雜種進行胚挽救

概念
胚挽救是指對由於營養或生理原因造成的難以播種成苗或在發育早期階段就敗育、退化的胚進行早期分離培養成苗的過程。
胚挽救技術發展歷史
胚挽救技術是植物體外培養領域最成熟的技術之一。
胚挽救的最早記錄可以追溯到18世紀,Charles Bonnet分離並培養了菜豆與蕎麥的胚並獲得植株;較為系統的胚挽救技術開始於20世紀初——1904年,Hanning首次在人工培養基上成功地系統培養出植物胚(兩種十字花科的成熟胚)。
1933年,Tukey首次報導甜櫻桃胚培養,是果樹胚培養的里程碑。
 胚挽救得到的植物
胚挽救得到的植物1982年,Ramming首次報導無核葡萄胚珠培養,獲得2株實生苗,而我國在20世紀90年代初開始無核葡萄胚珠培養研究。
胚挽救技術在各科屬植物中都得到廣泛利用,尤其是在果樹育種。
胚挽救技術的套用
培育早熟品種
核果類果樹中的早熟品種果實發育期短,胚發育不成熟,導致常規播種很難成苗,胚挽救技術能夠有效提高早熟品種的萌芽率和成苗率。
我國近50年內套用胚挽救技術培育出許多早熟和特早熟桃品種,如京早3號、春蕾、早花露,玫瑰露、丹墨、早紅霞、早美和雲露;而美國則選育出五月火和金冠等早熟桃品種。
培育無核品種
對種子敗育型的無核品種,在其合子胚敗育之前進行人工離體培養時期繼續發育,最終萌發成苗,形成完整的植株。
無籽葡萄品種楊格爾在化後27~33d胚就開始敗育,只有很少的胚能發育到球形或心形胚階段,利用胚挽救技術能夠克服胚的早期敗育獲得正常植株。
克服遠緣雜種不育
遠緣雜交是將野生種或近緣種屬有益基因導入栽培種,進行種植創新的有效途徑。
雜交不親和及雜種不育是遠緣雜交種的兩大障礙,受精前的雜交不親和可以通過選擇合適的雜交親本,特殊的授粉方式等方法克服;而受精後由於雜種胚、胚乳和子房組織之間缺乏協調性,導致幼胚不發育或敗育,是遠緣雜交工作的瓶頸。通過胚挽救途徑,在雜交幼胚敗育前進行離體培養可以避免遠緣雜種胚敗育獲得雜種植株。
培育三倍體及其它多倍體新種質
三倍體葡萄,柑橘等具有無籽,果大等優點。
一般獲得三倍體的有效方法是二倍體與四倍體雜交,由於二者間有生殖隔離,會使得雜種胚發生敗育。胚挽救技術的套用有效克服了這一障礙。
四倍體—甘藍型油菜(AACC)與二倍體親本種白菜(AA)以及甘藍(CC)各自雜交,利用胚挽救技術得到三倍體AAC以及ACC。
克服多胚品種珠心胚的干擾
柑橘、芒果等果樹具有多胚性,即在1個種子中有多個無性胚的現象。
柑橘中由於珠心胚在合子胚發育過程中旺盛生長進而侵入胚囊,阻礙合子胚的發育,造成敗育。這是柑橘雜交育種的障礙,為防止這種情況,在珠心胚侵入胚囊之前,將合子胚離體培養進行胚挽救,可排除珠心胚的干擾。
胚挽救的影響因素
胚發育包括自養和異養兩個階段:異養階段的胚較小需要外源營養及生長調節物質才能滿足發育的需要,胚主要從胚乳及周圍的母體組織吸收養分;自養階段胚的發育不依賴外源營養和生長調節物質,胚在代謝上能由基本的無機鹽和糖合成生長所需的物質,在營養上相對獨立。
胚由異養轉為自養是胚發育的一個關鍵時期,通常心形胚發育中期前是異養期,心形胚晚期轉為自養,隨著胚齡的增加,對外源營養要求趨於簡單。
基因型
不同品種的基因型、敗育特點等各不相同,胚挽救存在很大差異。
適宜取樣培養時間
胚齡:從授粉開始到剝離胚培養的時間天數。
胚齡是影響胚培養成功的關鍵因素之一,胚齡越小越難培養成功。胚齡與胚挽救成苗率呈正相關;但由於胚到一定階段會開始敗育,同樣會影響胚挽救成功的幾率,故應選擇胚發育到醉倒成都,但又尚未開始敗育的時期進行培養。
如桃開花後68d胚挽救的胚萌發率為70%;無核葡萄楊格爾品種在花後27~33d期間胚培養易成功;甘藍型油菜與其親本種雜交後的雜種在7~10d開始敗育,在此期間胚挽救容易成功。
培養基
不同幼胚使用的基本培養基有所不同,要依據不同植物選擇最適合的培養基。
同一品種,不同發育時期所選用的培養基不同,如油菜雜種在胚培養時期選用1/2 MS培養基,而在胚萌發後則需要轉移到MS培養基上。
培養環境
低溫處理:
核果類未熟胚培養是,低溫處理對胚萌發有促進作用;
其他條件:光照、濕度以及培養容器都影響胚挽救的效果。
胚挽救具體步驟
以四倍體甘藍型油菜與二倍體甘藍雜交後獲得雜種為例:
甘藍型油菜與甘藍雜種進行胚挽救
甘藍型油菜與甘藍雜種進行胚挽救田間採取人工去雄授粉的方法,雜交7-10d取子房,首先進行預處理:70%乙醇(30s)→無菌水(1min)→10%NaClO(15-20min),期間輕輕晃動使之充分消毒→滅菌水清洗三次(5min)。滅菌完成後用解剖針沿腹線將子房剝開,輕輕將胚珠剝離放在1/2MS培養基(1/2MS+3%蔗糖+0.8%瓊脂)上,遮光並放在適宜溫度條件下直到胚萌發。將長出的胚組織轉移到快繁培養基(MS+3%蔗糖+0.8%瓊脂)直至成苗,成苗後將無菌苗再轉移到分化培養基(MS+3mg/L 6BA+0.2mg/L NAA+3%蔗糖+0.8%瓊脂)形成無性系。

